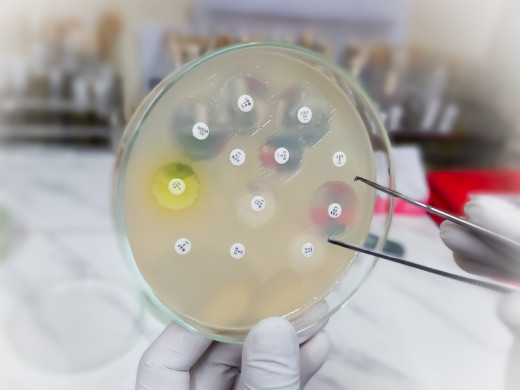
Do 30 let mohou infekce zabíjet častěji než rakovina

Desítky ukrajinských lékařů pomáhají v ordinacích praktiků
Od začátku války na Ukrajině zaměstnali čeští praktici téměř padesát lékařů, kteří ze země před konfliktem uprchli. V ordinacích ale zatím plní roli asistentů, kteří praktikům pomáhají především s ukrajinskými pacienty. Léčit dosud nemohou, brání tomu komplikovaný proces tzv. nostrifikace a zejména aprobace. Řada ukrajinských lékařů by přitom chtěla v Česku zůstat a ordinovat. Jak jim v tom pomoci, budou řešit stovky praktiků na nadcházející XVII. jarní interaktivní konferenci Společnosti všeobecného lékařství (SVL) ČLS JEP, která se koná 12.–14. května v Praze.
Už přes rok trvá projekt Ukrajina, do kterého se zapojilo téměř pět desítek ukrajinských lékařů a kolem dvaceti ordinací praktiků. „Je to výhodné pro všechny strany: ukrajinský pacient, kterému se život obrátil vzhůru nohama a přišel o všechny jistoty, může mluvit s lékařem ve svém rodném jazyce, ukrajinský lékař může pracovat v oboru a českému lékaři ulehčí práci s ukrajinskými pacienty. Pro české pacienty se díky takto navýšené kapacitě neprodlužují čekací doby a pro stát je výhodné, že ukrajinský lékař má placené zaměstnání a nepobírá sociální dávky,“ říká MUDr. Cyril Mucha, místopředseda SVL ČLS JEP a hlavní koordinátor projektu Ukrajina. Ten vznikl v reakci na příliv ukrajinských uprchlíků, z nichž řada potřebovala zdravotní péči a mezi nimiž byli zároveň i lékaři. Počty zapojených ukrajinských lékařů se průběžně mění, protože někteří přišli do Česka později, nebo už se naopak vrátili zpět na Ukrajinu. Mezi těmi, kteří zatím zůstávají, je Oksana Denysiuk z Kyjeva, jež před válkou uprchla v březnu minulého roku. „Od listopadu pracuji v pražské ordinaci a jsem moc spokojená, že mohu pracovat ve svém oboru, i když ne vyloženě jako lékařka,“ popisuje Denysiuk, která v ordinaci pomáhá především při péči o své krajany. Tak jsou ostatně zapojení i další lékaři a lékařky, kteří z Ukrajiny uprchli. „Když přijde do ordinace ukrajinský pacient, ujme se ho zaměstnaný lékař z Ukrajiny, projde jeho anamnézu a zjistí hlavní problémy. Český lékař potom na základě zjištěných informací stanoví diagnózu a navrhne terapii,“ vysvětluje MUDr. Mucha. V rámci konference bude oceněna děkovným listem i praktická lékařka MUDr. Anna Matoušková, která doslova v prvních dnech ruské agrese vytvořila a dodnes udržuje web www.lekariproukrajinu.cz, který je skutečnou studnicí informací pro všechny, kdo s utečenci jakkoli pracují. Na projekt Ukrajina vyhradila SVL milion korun a tři čtvrtě z něj už využila. „Ordinace, které zaměstnávají ukrajinského lékaře jako asistenta, dostávají příspěvek deset tisíc korun měsíčně. Také jim na začátku pomůžeme s administrativou, která je spojená s přijetím lékaře a je dost komplikovaná,“ popisuje doc. MUDr. Svatopluk Býma, předseda SVL ČLS JEP. Zda bude SVL po vyčerpání prostředků vyhrazovat další, ještě není jasné. Otazníkem je i budoucnost ukrajinských lékařů, kteří v Česku chtějí zůstat. Zatím není jisté, kolik by jich chtělo ordinovat v Česku, protože kvůli nestabilní situaci v jejich domovině nemohou dopředu nic plánovat. Jista si není ani Oksana Denysiuk. „Záleží, jestli budu moci pracovat jako lékařka. Ale určitě bych se o to chtěla pokusit,“ říká. Aby mohli Ukrajinci pracovat jako lékaři v Česku, musí mít nejdřív tzv. nostrifikaci – uznání zahraničního vzdělání, potom složit první část aprobační zkoušky a absolvovat půlroční stáž v nemocnici, kterou si sami platí. „Je otázka, z čeho budou mezitím žít. Je to běh na dlouhou trať. Z pozice praktiků jim těžko můžeme pomoci. Chceme zatlačit na stát, aby pro ně upravil podmínky. Pomohlo by, kdyby například udělil ukrajinským lékařům dočasnou výjimku, že mohou pracovat pod dohledem českého lékaře nebo že by půlku stáže absolvovali v ordinacích u praktických lékařů. Případně by stát mohl podpořit nemocnice, aby ukrajinské lékaře v rámci aprobační stáže zaměstnaly,“ navrhuje MUDr. Mucha.